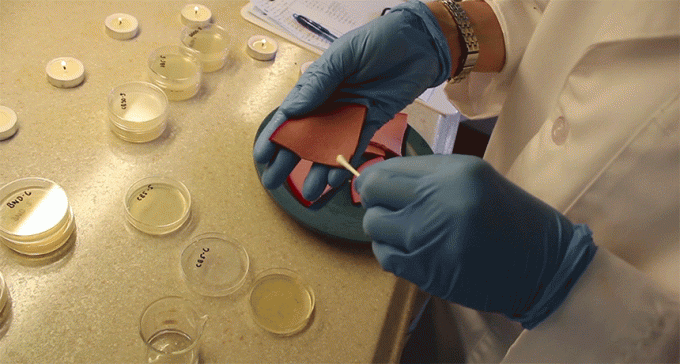

Collection
Experiments
This series is meant to teach about how science is done, from generating a hypothesis to designing an experiment to analyzing the results with statistics. You can repeat the steps of one of these experiments and compare your results — or use this as inspiration to design your own experiment.